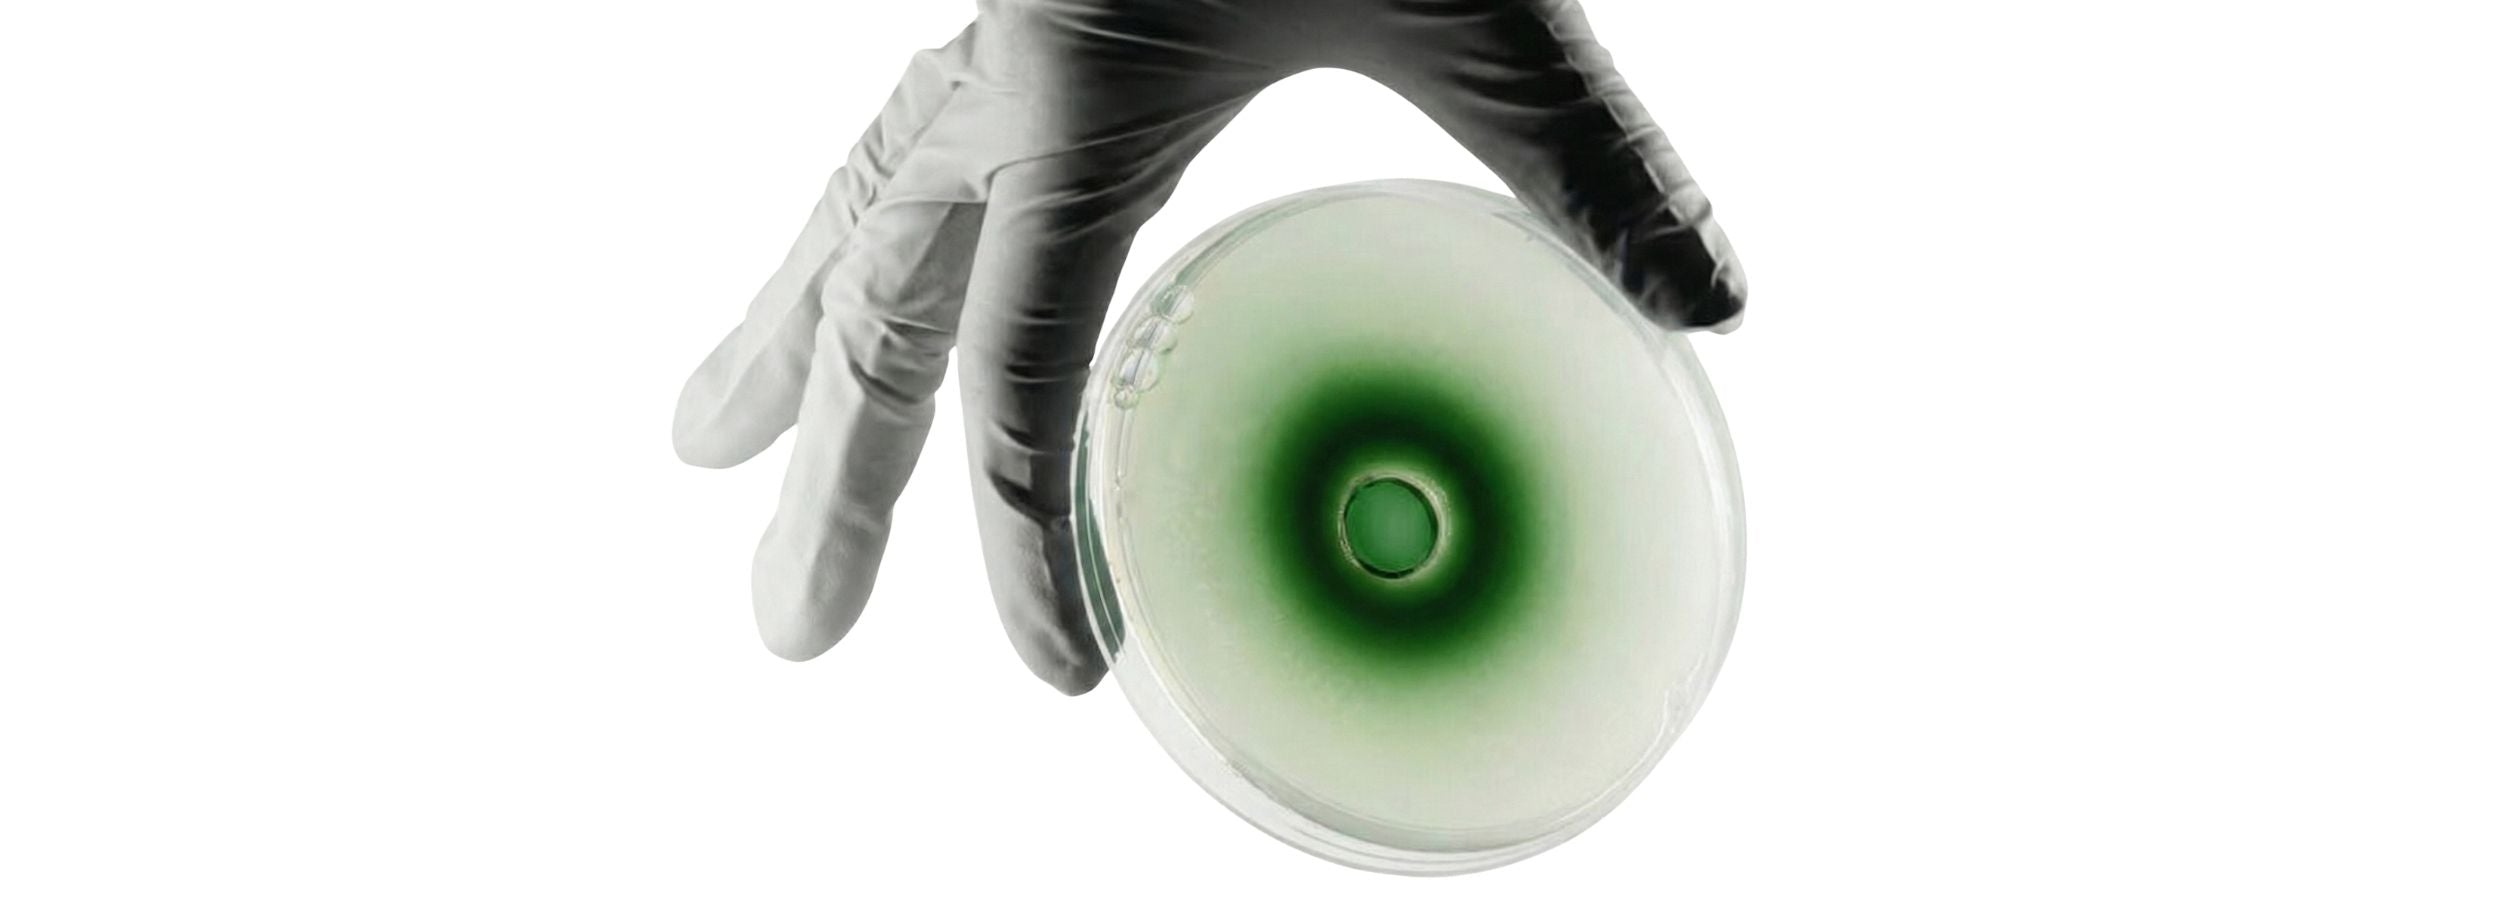

I've always been more into skincare than most guys my age, and wrinkle care has been on my radar for a while. I wanted something that actually works without going the clinic route. After checking the ingredient list and reading some genuine reviews, I decided to order.
First impression: the packaging is incredibly premium. I genuinely thought it was a European luxury brand when it arrived. Turns out it's K-Beauty, which made me even more impressed.
The serum is a rich golden liquid but absorbs surprisingly fast. No greasy residue, just a smooth bouncy finish. One pump covers my entire face, so the bottle will last a while.
I've been using it as a post-shave step instead of my usual toner and the calming effect is noticeably better. After just a few days, my skin feels visibly smoother and the hydration actually lasts through the day.
Still early days for judging the anti-wrinkle results but I'm already satisfied. For men in their 40s and 50s looking for a serious skincare upgrade, this is worth trying.
I bought this together with the serum from the same brand. I've tried quite a few spicule creams over the years but kept seeing "Shorticule" mentioned and wanted to know what the difference actually was. I'm at the stage where wrinkle care is a real priority, and I've used plenty of products that all claim to work but never really knew if they did anything.
What caught my attention here was the Shorticule technology, which is apparently a milled and upgraded version of regular spicules, combined with 24K gold. Pairing that with the serum seemed like a solid combination.
Packaging wise, it looks like a high end European luxury brand. Premium feel from the moment you open the box. The gold spatula that comes with it genuinely surprised me. I always use a spatula with jar creams to avoid bacterial contamination, but this one is a step above anything I've seen. Feels like something you keep on your vanity permanently.
Scooped out a tiny amount and it covered my whole face easily. I was expecting the tingling sensation spicule products are known for but it was much milder than expected. Actually quite comfortable.
One jar in and I can already see why this brand positions itself as a premium K-Beauty line. Curious to try the other products in the range too.
This Superface micro-spicule cream is simply beautiful. You can tell an artist created this packaging as it has a sexy appeal to it and the product itself has tiny gold speck throughout. It really does have a bit of a tingling sensation. I’ve used a few of these creams and the other I have tried seems strong and persistent whereas this is a burst of feels then fades out. I can layer this as well if I dont rub too much. I use it every other day to a few days a week because it can be a bit much. However, it has evened out skin texture and has made my face smoother and more moisturized. Pricey, but you get what you pay for.
The cream is very soft and light but still substantial enough to require it to be rubbed in - which is great for the penetration of ingredients. It spreads easily. It has no greasiness. It has many beneficial properties in the ingredients so the spicules can deliver them deep within the skin. I like that niacinamide is one of the first ingredients. It also has other great skin builders like natural extracts and Centella sciatica. The coffee extract will give the skin a nice boost of circulation. I personally find that I need to layer another moisturizer over top if I want to feel deeply hydrated, but I do believe that this will give good results in terms of spicule creams compared to others that are more expensive. You can feel the spicules, but they are not uncomfortable. It is perfect.
This cream feels luxurious and moisturizing, and delivers noticeable results. The formula absorbs quickly and leaves skin looking smoother, brighter, and more even over time. The tingling sensation is not for the faint of heart - it feels like a lot of tiny needles - but it feels like a professional treatment at home. A great option for anyone focused on texture, tone, and anti-aging care. Little to no scent.